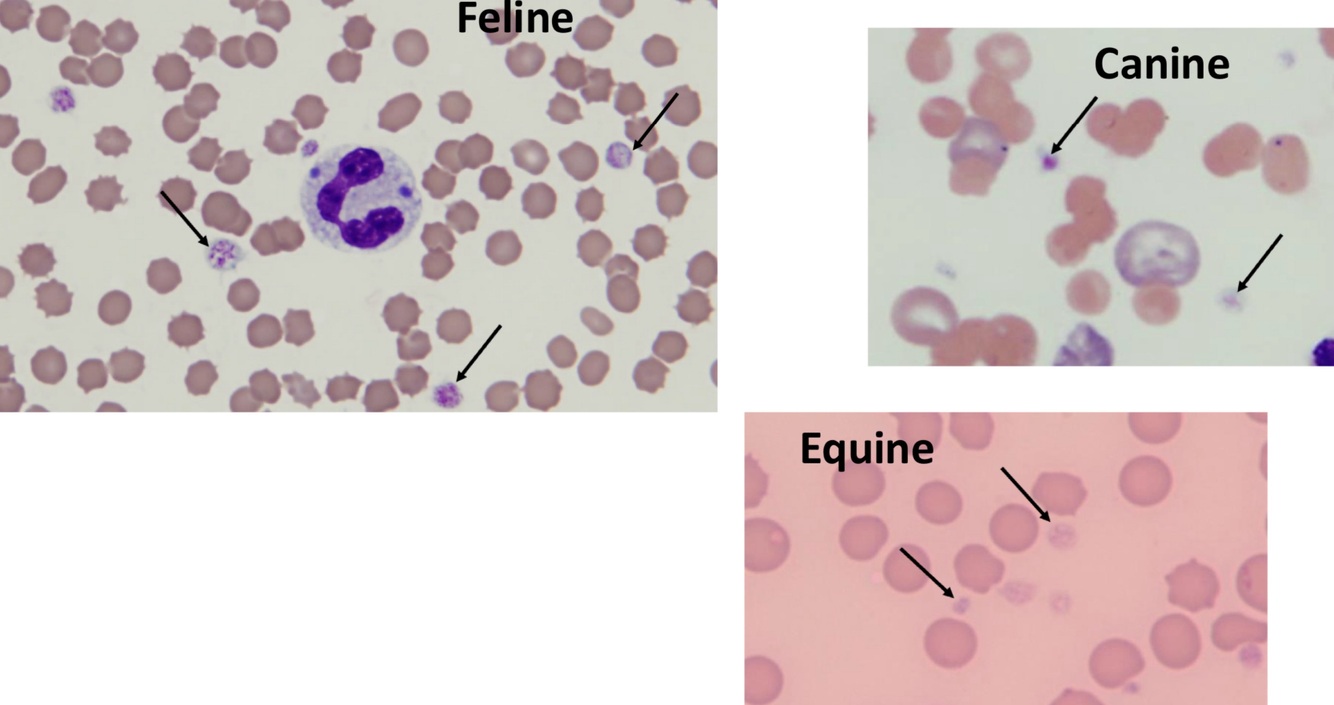

Hemostasis
+
Primary v Secondary
arrest of bleeding or interruption of blood flow
abnormalities cause hemorrhage or prothrombus
Primary = endothelial response + formation of platelet plug
Secondary = coagulastion cascade + clot resolution
Major players in hemostasis
blood vessels
platelets
coagulation factors
fibronilytic factors
Healthy Endothelium
Normally in antithrombotic state
1) antioplatelet factors:
- blo subendothelial extracellular matrix
- produce prostacyclin + NO
2) anticoagulant factors
- heparin like molecules
- thrombomodulin
- tissue factor pathway inhibitor
3) fibrinolytic factors
- tissue-type plasminogen activator

Injured Endothelium
local neurologic response after injury 🡒 arteriolar constriction
- attempt to ↓ defect size
prothrombotic properties during trauma + inflammation
subendothelial EC matrix now exposed to platelets 🡒 adhesion thru vWF
- vWF synthesized + stored in endothelial cells
procoagulant tissue factor produced in response to inflammation
release of plasminogen activator inhibitor
- inhibits fibrinolysis
- favors thrombosis
Megakaryopoiesis + Regulation
- almost all mature forms in marrow = < 1% nucleated cells
- multinucleate cell with lobulated nucleus = forms by endomitosis
- maturation time 2-10 days
Thrombopoietin
- from liver + kidneys + marrow stromal cells
- produced at constant rate in health
- 🡑 # of progenitor cells
- 🡑 megakaryocyte size + ploidy
- 🡑 releases of platelets
🡑 thrombopoeitin production stimulated by:
- 🡓 in megakaryocyte + platelet mass
- IL-6, GM-CSF, stem cell factor

Platelets
- anucleate cytoplasmic fragments
- released directly into blood
- 30-40% in spleen
- life span = 5-9 days
- removal 🡒 phagocytosis by macrophages
Avian + Reptiles + Fish + Amphibians
Thrombocytes
platelets known as thrombocytes instead
- nucleated
- high nuclear to cytoplasmic ratio
- may be difficult to distinguish from lymphocytes
- from distinct mononuclear cell line

Platelet Phases of Hemostasis
1) Adhesion 🡒 mediated primarily by vWF
- bridge between platelet + exposed collagen
- release from endothelial cells + platelets
2) Shape Change
- from discound to spherical
- formation of pseudopodia
3) Aggregation
- activated platelet receoptor binds fibrinogen + vWF 🡒 forms bridge between platelets
- Thromboxane A2 amplifies 🡒 produced during platelet activation
4) Granule Release
- activates platelet phospholipases 🡒 TXA2 production
- release Ca2+ 🡒 componenet of coag cascade
- release of factors V + XI + vWF
- translocation of phosphotidylserine 🡒 binds Ca2+ = focused coagulation
Platelet Count
measured in EDTA anticoagulated blood
clumping may falsely 🡓
- very common in cats + cattle
can be estimated on blood smear
- avg # in monolayer (100X objective) x 15-20K
- can look for large platelets
< 20,000/uL concern for spontaneous bleeding
May get other parameters:
- mean platelet volume (MPV)
- platelet distribution width (PDW)
- thrombocrit
Thrombocytopenia Mechanisms
1) 🡓 production
- drugs = chemo, chloramphenicol, sulfa drugs, etc.
- toxins = aflatoxin, bracken fern
- infectious = FeLV, parvo, ricketssial diseases etc.
- proliferation of neoplastic cells in bone marrow
2) 🡑 destruction
- immune mediated = IMHA or ricketssial disease
- increased activation = DIC, infection
3) Sequestration
- splenic congestion/neoplasia
4) 🡑 consumption/utilization
- hemorrhage/trauma rare
- DIC
Macrothrombocytopenia of Cavalier King Charles Spaniels
release of platelets from megakaryocytes abnormal
counts 30,000 - 100,000/uL (200K-700K/uL
have large platelets
plateletcrit often normal
doesn’t cause bleeding
Thrombocytosis Mechanisms
1) splenic contraction
2) reactive thrombocytosis
- inflammation
- neoplasia
- iron deficiency
3) megakaryocytic leukemia / myeloproliferative disorders
Thrombopathy
functional platelet disorder
Buccal Mucosal Bleeding Time
evaluates primary hemostasis
requires special lancet tool
do not use if thrombocytopenic
helpful to confirm thrombopathy 🡒 may be prolonged in von Willebrand disease
in dogs 🡒 usually < 4 min
Von Willebrand Disease (vWD)
vWF in entholial cells + platelets
- responsible for platelet adherance
- binds Factor VIII 🡒 🡑 half-life
small + medium + large multimers
- large most active
common in dogs, rare in other species
clinical signs when conc. < 20-35%
3 types
3 types of vWD
Type I = 🡓 in multimer sizes
- plasma conc. < 50%
- multimers present structurally + functionally normal
- majority of canine cases (doberman pinschers)
Type II = disproportionate loss of large multimers
- Rare
Type III = severe decreases in all multimers
- conc. often < 0.1% of normal
vWD testing
need plasma sample
- citrate or EDTA sample
- free of clots + hemolysis
- recommended to seperate plasma, place in plastic tube + freeze
measured by species specific Ab to vWF
multimeric analsysis possible
most dogs that bleed have values < 35%
genetic testing available
Intrinsic Disorders of Platelet Function
Chediak-Higashi syndrome
- platelets lack dense granules 🡒 lack platelet/coagulation activators
Cyclic Hematopoiesis of Grey Collies
- platelet reactivity to some activators defective
- dense granules absent
Acquired Disorders of Platelet Function
Cyclooxygenase inhibiting drugs
- inhibits TXA2 production
- aspirin = irreversible (up to 5 days)
- non-selective NSAIDS = reversible (usually only hours)
Uremia
- inhibits fibrinogen binding
- alters interaction with vWF
- 🡑 NO + prostacyclin activity
Hyperglobulinemia
- interferes with platelet adhesion
Clinical Signs of Primary Hemostatic Disorder
- petechia
- ecchymoses
- bruising
- spontaneous hemorrhage when platelets < 20K/uL
- vWD 🡒 mucosal hemorrhage, prolonged bleeding from wounds
Clinical Signs of Secondary Hemostatic Disorder
large accumulations of blood:
- hematoma
- bleeding into cavities
- melena
- rebleeding from wounds
- hematuria
Coagulation
activation of pathways
- intrinsic with collagen exposure
- extrinsic with endothelial cell disruption
activation of FX
formation of thrombin
formation of fibrin

Intrinsic Pathway
Coagulation
stimulated by exposure of collagen (subendothelial ECM)
- negatively charged surface
Factor XII (FXII) initiates 🡒 activated by contact with neg. charges
cascade of enzymatic reaction 🡒 results in activation FX

Extrinsic Pathway
Coagulation
stimulated by tissue factor:
- from damaged tissue
- from activated cells (monocytes/macrophages)
TF + activated FVII activate FX
- can also activate FIX
Factor VII 🡒 shortest half-life of factors





